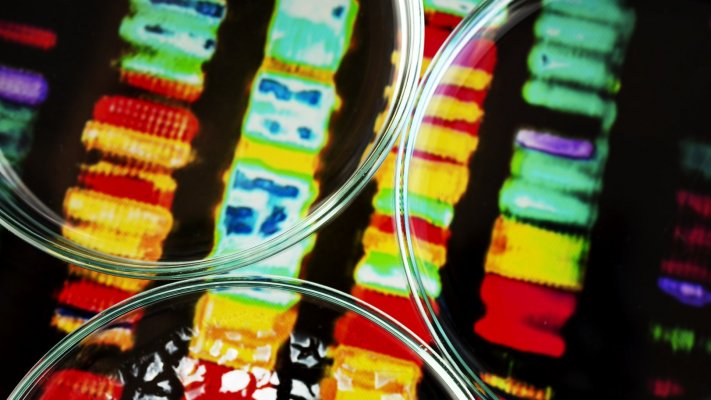

Cientistas criam sonda fluorescente para estudar partes celulares pouco conhecidas
Investigadores do Instituto Federal Suíço de Tecnologia de Lausanne (EPFL) desenvolveram uma sonda fluorescente que visualiza centríolos e cílios em células vivas, um avanço significativo no estudo de componentes cruciais, mas relativamente desconhecidos.
Os centríolos guiam a divisão celular, enquanto os cílios atuam como "antenas sensoriais" vitais para a comunicação e motilidade celular, explicou um comunicado de imprensa da EPFL citado na segunda-feira pela agência Efe.
As sondas fluorescentes transformaram a biologia celular nos últimos anos, permitindo a observação em tempo real das estruturas celulares.
No entanto, as sondas existentes não conseguiam distinguir entre centríolos e cílios devido à sua estrutura semelhante à dos microtúbulos.
A nova sonda, denominada 'GenSpark', poderá auxiliar no combate a determinadas doenças genéticas ou cancro, por vezes associados a defeitos na formação ou função destas duas estruturas.
A equipa que desenvolveu a sonda é liderada por Pierre Gönczy e colaborou com várias instituições, incluindo o Instituto Ludwig para a Investigação do Cancro (Alemanha) e a Universidade de Utrecht (Países Baixos).

Mundial 2026: Ventura desafia federação a convidar crianças com cancro ou antigos combatentes

Ébola: Epidemia na África Central preocupa Governo, mas risco é baixo - MNE

PCP preocupada com falta de médicos anestesistas no Hospital da Feira

Primeira unidade pública para dependência do jogo a dinheiro abre quinta-feira em Lisboa

Médico Peter Barnes recebe grau Doutor Honoris Causa pela Universidade de Coimbra

Novos Núcleos de Saúde Familiar em funcionamento em Angra do Heroísmo

Sindicato vai distribuir minuta para médicos contestarem nova forma de calcular horas extra

Médicos têm de trabalhar 300 horas extra acima do limite para ganhar o mesmo - FNAM

Horas extra nas urgências podem valer entre 45% e 85,5% do salário aos médicos

LEIRIA: Hospital com novo programa de eletrofisiologia

Ordem dos Médicos recebe até 6 queixas/mês por conflitos e violência psicológica
